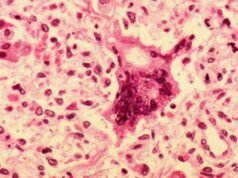
Measles spreading undetected in Sydney, NSW Health warns

Source : ABC NEWS

Three-time Melbourne Cup winner Makybe Diva has died at 26 after a sudden health battle with colic.
The champion racehorse combined with jockey Glen Boss to create history between 2003 and 2005, and is still the only horse in history to win the Melbourne Cup three years in a row.
“From the day she came into our lives, she was never just a racehorse, she was family,” Makybe Diva’s owner Tony Santic said in a statement on Saturday afternoon.
“She gave us moments Australia will never forget, but more than that, she gave us joy every single day. She was loved from the beginning, and she stayed loved for her whole life.”
Makybe Diva was inducted into the Australian Racing Hall of Fame in 2006 following a tremendous 2005 season which saw her also take out the Cox Plate, Australian Cup, BMW Stakes, Memsie Stakes and Turnbull Stakes alongside the Melbourne Cup.
Loading